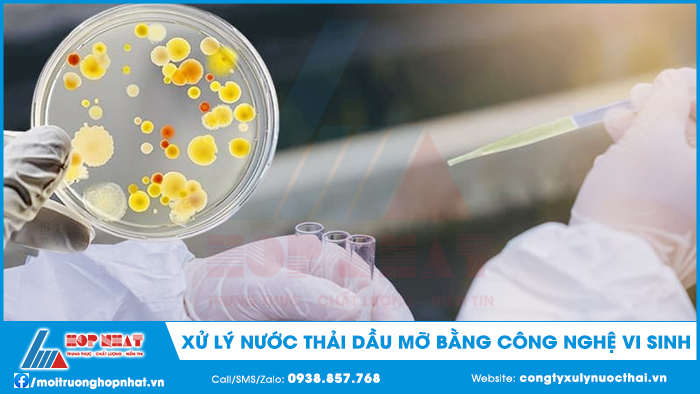
Xử lý nước thải dầu mỡ bằng công nghệ vi sinh

Mặc dù nước thải dầu mỡ không chứa nhiều chất độc hại so với những hóa chất khác, nhưng dầu mỡ lại tác động khá lớn đến môi trường. Bởi lẽ dầu mỡ thực chất là những chất khó phân hủy nếu không có lực tác động từ bên ngoài. Dầu mỡ khi xả ra ngoài môi trường là nguyên nhân làm hệ sinh vật phát triển kém, giảm nồng độ oxy, phá vỡ chuỗi thức ăn của các loại động vật phù du. Vì vậy các nhà hàng, quán ăn, cần lắp đặt hệ thống xử lý nước thải dầu mỡ hiệu quả để bảo vệ môi trường.

1. Xử lý nước thải dầu mỡ bằng công nghệ vi sinh
Nếu sử dụng hóa chất không an toàn vì để lại dư lượng khá lớn thì việc ứng dụng vi sinh không làm ảnh hưởng lớn đến môi trường và sức khỏe của con người. Đối với vi sinh xử lý nước thải hoàn toàn an toàn và thân thiện bởi hệ thống vsv có lợi có khả năng phân hủy hết dầu mỡ, chất hữu cơ.
Vi sinh sử dụng dầu mỡ và chất bẩn làm thức ăn để sinh trưởng và tăng sinh khối giúp làm biến đổi thành phần cấu tạo của chất thải. Đặc biệt, sử dụng vi sinh xử lý nước thải mang lại rất nhiều lợi ích như:
- Loại bỏ chất bẩn và hạn chế mùi hôi khó phân hủy.
- Loại bỏ váng dầu mỡ dễ dàng mà không làm hư hỏng đường ống dẫn nước.
- Quá trình vệ sinh nhanh chóng, đơn giản, an toàn.
- Tiết kiệm chi phí, bảo trì và bảo dưỡng hệ thống xlnt hiệu quả hơn.
- Đảm bảo nguồn nước trong các giai đoạn xử lý phía sau diễn ra thuận lợi.
2. Xử lý nước thải dầu mỡ bằng phương pháp tuyển nổi
So với 2 phương pháp trên thì phương pháp này cũng hiệu quả chẳng kém. Bể tuyển nổi có khả năng loại bỏ dầu mỡ, hạt phân tán nhỏ nhờ các bọt khí tan kéo theo chất vô cơ, chất hòa tan ra bên ngoài.
Đặc biệt, xử lý nước thải quán ăn người ta thường xây dựng bể tuyển nổi để loại bỏ dầu mỡ trong quá trình nấu ăn và vệ sinh. Phương pháp này hoạt động dựa trên sự phân tán hạt có khả năng tự lắng kém. Tuy nhiên, chúng có thể dễ dàng kết dính vào các bọt khí nổi lên trên bề mặt nước. Tiếp theo, người ta sẽ tách bọt khí cùng nhiều phần tử dính ra khỏi nước. Về cơ bản, đây là quá trình tách bọt hoặc làm đặc bọt kéo theo nhiều chất hòa tan, cặn bẩn và dầu mỡ nổi lên trên bề mặt.
Để vận hành hệ thống này, bắt buộc phải tiến hành thổi khí để hình thành bọt khí trong nguồn thải. Những bọt khí kết dính hạt lơ lửng tập hợp thành bông hạt đủ lớn chứa nhiều hạt bẩn ô nhiễm.
Những lý do để bể tuyển nổi ghi điểm tuyệt đối trong việc xử lý dầu mỡ đó chính là nó có thể thích nghi tốt với tải trọng lớn, hiệu quả xử lý cao với thời gian lưu nước nhỏ. Thiết bị này nhỏ gọn, ít tốn diện tích, lắp đặt dễ dàng, tiêu thụ điện năng thấp hoặc giảm lượng hóa chất sử dụng.

3. Xử lý nước thải dầu mỡ bằng phương pháp cơ học
Đây là giải pháp xử lý nước thải phổ biến nhất trong các HTXLNT vì nó khá hiệu quả trong việc tách dầu mỡ ra khỏi nguồn thải. Trong đó, nước thải nhiễm dầu mỡ chảy vào bể tách dầu theo phương nguyên lý nổi lên trên mặt nước. Tại các bể xử lý nước thải thì thức ăn thừa, cặn bẩn lắng xuống dưới đáy và chỉ cho phép phần dầu nổi theo bọt khí lên trên, phần nước sạch theo đường ống thoát ra bể thu gom.
Đa phần mọi nguồn thải đều chứa hàm lượng dầu mỡ nhất định, vì thế bạn cần phải tìm kiếm phương pháp xử lý phù hợp nhất. Bên cạnh những phương pháp trên, Công ty môi trường Hợp Nhất còn rất nhiều kinh nghiệm và công nghệ trong xử lý nước thải hiện đại khác. Nếu Quý Doanh nghiệp có nhu cầu thiết kế vui lòng liên hệ ngay Hotline: 0938.857.768 để được hỗ trợ nhiều thông tin khác.
